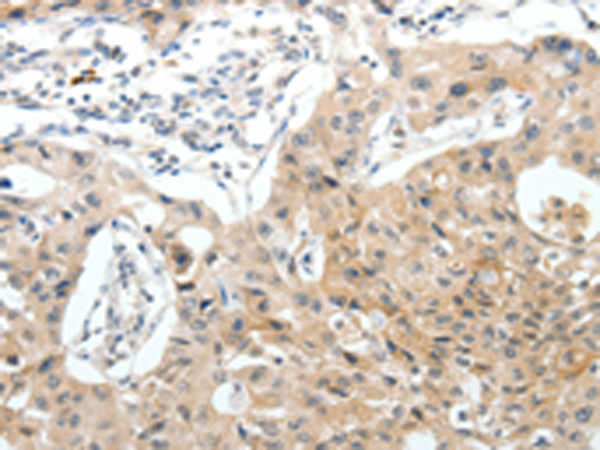

-
分类: 科研抗体货号: P11409别名: Fz10; FzE7; CD350; FZ-10; hFz10应用: IHC反应种属: Human, Mouse
-
分类: 科研抗体货号: P11389别名: TMSA应用: IHC反应种属: Human, Mouse, Rat
-
分类: 科研抗体货号: P11399别名: EDG2; LPA1; VZG1; GPR26; edg-2; vzg-1; Gpcr26; Mrec1.3; rec.1.3应用: WB,IHC反应种属: Human, Mouse, Rat
-
分类: 科研抗体货号: P11408别名: FZ-8; hFZ8应用: IHC反应种属: Human, Mouse, Rat
-
分类: 科研抗体货号: P11398别名: L3; LASS2; SP260; TMSG1应用: WB,IHC反应种属: Human, Mouse
-
分类: 科研抗体货号: P11387别名: CD90应用: IHC反应种属: Human, Mouse, Rat
-
分类: 科研抗体货号: P11407别名: hFat3; CDHF15; CDHR10应用: IHC反应种属: Human, Mouse, Rat
-
分类: 科研抗体货号: P11397别名: TRX; TRDX; TRX1应用: WB,IHC反应种属: Human, Rat
-
分类: 科研抗体货号: P11386别名: TIE2; VMCM; TIE-2; VMCM1; CD202B应用: IHC反应种属: Human, Mouse
-
分类: 科研抗体货号: P11406别名: FATJ; FAT-J; CDHF14; CDHR11; HKLLS2; VMLDS2; NBLA00548应用: IHC反应种属: Human

鄂公网安备42018502007531号
鄂公网安备42018502007531号

